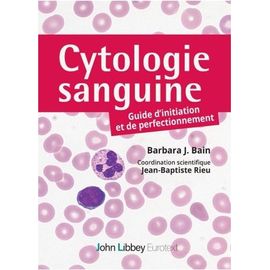
Cytologie Sanguine - Guide D'initiation Et De Perfectionnement

Livres Spécialités médicales Onco-hematologie(516 résultats
)
Livres Spécialités médicales Onco-hematologie
- Accueil
- Livres
- Santé
- Spécialités médicales
- Onco-hématologie
Nos experts vous recommandent
Recherches populaires
PUBLICITÉ